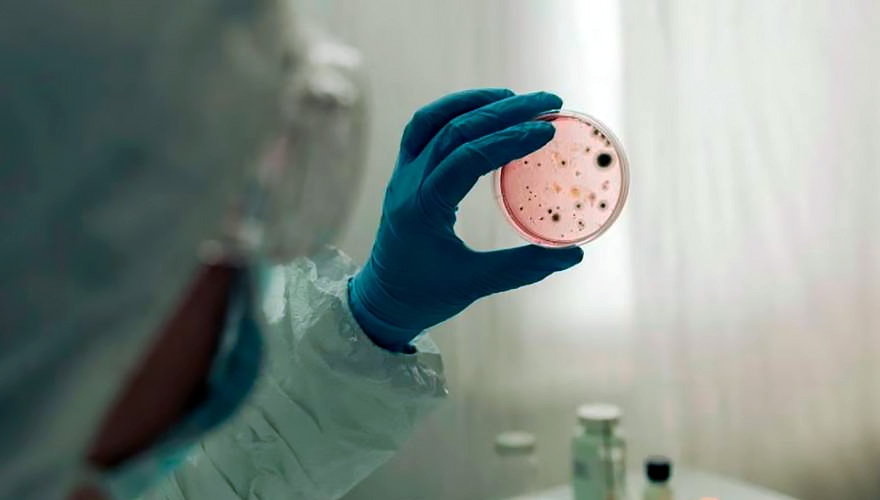

Giinebra.- La Organización Mundial de la Salud (OMS), advirtió este martes de una escalada del brote mundial de cólera a causa de la intensificación de los efectos del cambio climático.
El organismo pidió un aumento urgente de la financiación para apoyar los planes de respuesta a esta crisis sanitaria.
«A medida que se intensifiquen los efectos del cambio climático, cabe esperar que la situación empeore, a menos que actuemos ahora para impulsar la prevención del cólera», afirmó el responsable del equipo de la OMS contra el cólera, Philippe Barboza.
Barboza advirtió que, desde el pasado enero, cuando este brote fue clasificado por la organización sanitaria como una emergencia de grado tres, el nivel de alerta más alto, la situación «no ha hecho más que empeorar».
Tomado de Unión Radio